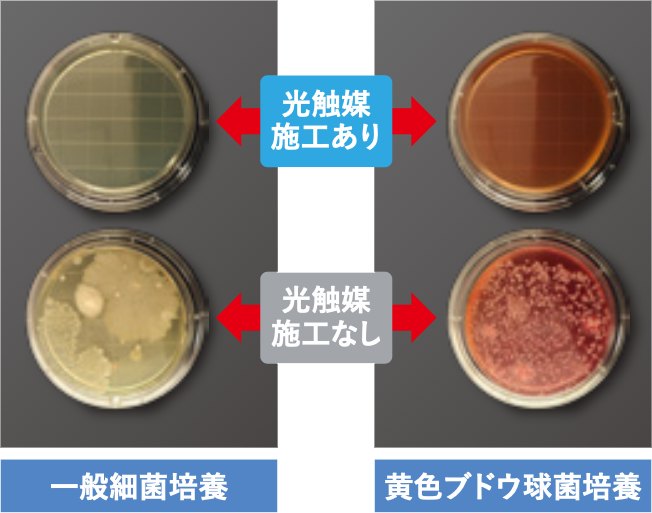

LuxAir〈ルクセア〉とは
間接照明と空気清浄機を融合させた
斬新なデザイン。
光で空間を照らしながら除菌を行う、
新しいタイプの
「空間除菌照明装置」です。
特許取得済の抗菌LEDライトが「光触媒」を活性化、「銀イオン」と「銅イオン」の二重のパワーを空間全体に広げることで、有害な細菌やウイルス、臭いの原因物質、カビ、花粉を除去します。
無菌手術室と同じ流層プロセスを応用。空間内にちりや埃を舞い上げずに静かに確実に空間を洗浄します。LED光源を採用しており、省エネ性能に優れ、50,000時間以上の長寿命を実現しています。
抗菌の即効性を高めた
新しい光源システム
WARP LIGHT(特許取得済)
-
WARP LIGHTは、高性能、高品質な光触媒(酸化チタン)の能力を最大限に生かす為に、可視光線と紫外線(人体に無害な波長域)を加える事で効率的な光触媒作用を実現致しました。
更に、光触媒に銀と銅イオンを配合し散布させる事により空気中の雑菌に対しても抗菌の相乗効果が得られます。 -
NASAで認められた技術。
高性能の光触媒を採用。
-
NASAで認められた光触媒チタニア1.0を採用。この光触媒は菌やウイルスの無力化に最適な濃度(一般的に光触媒と言われているものよりはるかに高濃度)で、独自の技術と製法で粒子が細かく(水溶性酸化チタン)、より確実に菌やウイルスを無力化し、密着性が高く長期間の効果持続に成功した製品です。
さらに、特許技術の「光触媒に配合した銀イオン、銅イオン」が帯電により空気中にすみずみまで浮遊し空間を除菌していきます。 -
LuxAirの特徴
-
空間清浄の最適化
連続稼働することにより、常に清浄空間が保たれます。

-
省エネ設計
一日12時間可動しても約7円。
一か月使用しても電気料金はリーズナブルです。
(一か月217円/東京電力調べ)
※電気料金は電力会社のプランによって変わります。
-
設置工事なし
100Vコンセントがあればどこにでも設置が可能です。
WARPLIGHTの取り付けができない場所や天井が高い空間に最適なデザインです。
活用シーン
LuxAirはあらゆるシーンを浄化し、
ご家族に安心をご提供します。
試験データ
新型コロナウィルスに有効
-
新型コロナウィルスに有効
光触媒単体:群馬大学においてWARP LIGHTが採用する光触媒は新型コロナウィルス不活化試験で99%の報告をいただいております。
WARP LIGHT:2022年1月22日株式会社食環境衛生研究所にて新型コロナウイルスの不活化試験で99%の報告をいただいております。 -
SARS-CoV-2 試験結果(TCID50/mL)
以上の結果より、SARS-CoV-2に対して8時間の反応で
99.0%の感染価の減少が見られた。
-
インフルエンザウイルスに有効
インフルエンザウィルスの不活性化試験でも効果を得られています。
A型インフルエンザ(H1N1)
ウイルス不活性化試験
-
大腸菌・黄色ブドウ球菌に有効
第三者機関で、大腸菌や黄色ブドウ球菌、サルモネラ菌、レジオネラ菌、緑 膿菌、枯草菌芽胞、カンジタ菌、陽炎ビブリオ、リステリア菌に対して、33m2の容積空間で2mからの光照射で24時間で99.9%を除菌
アンモニア・ホルムアルデヒドのニオイを分解
ニオイの元となる雑菌や人体に有害なホルムアルデヒドなども分解します。
浮遊する花粉・ダニ・PM2.5を分解
PM2.5、花粉も分解。季節の変わり目にも安心してお使いいただけます。
LuxAir製品仕様

■高さ: 約1,370mm(CO2センサーなし) ■重量:約12kg ■電気料金:0.6円/1時間(東京電力調べ) ■入力電圧:AC100V ■消費電力:35W











